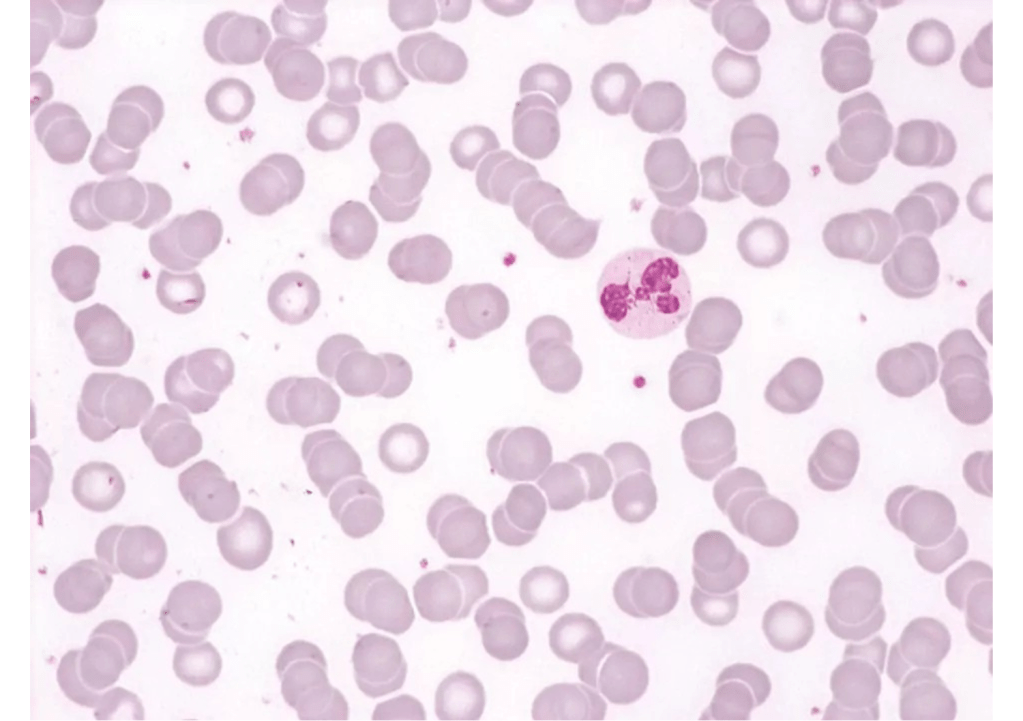

Puan Maimon is a 67-year-old female who has complaints of worsening fatigue and persistent bone pain, particularly in the lower back for the past 6 months.

History
Maimon had noted gradual deterioration in her health condition over the past 6 to 12 months. Although she had experienced aches and pains before, her back pain had become increasingly worse lately. She reports that the pain is dull and persistent, worsening with movement but not relieved by rest. Over the past two months, she has experienced increasing weakness and shortness of breath on exertion. There is no history of recent trauma, joint swelling, or morning stiffness.
Additionally, she has noted frequent episodes of cough and fever. In the past three months, she had already made two visits to her general practitioner for chest infections, for which she had been prescribed some antibiotics which afforded temporary relief. She has had unintentional weight loss of approximately 5 kg over the last three months and occasional dizziness. Her appetite is good and she has had no gastrointestinal symptoms such as abdominal pain, bloating, vomiting or change in bowel habits.
Maimon has no previous medical history of significance. She has no known history of autoimmune diseases or malignancy in the family and is not on any medications. She is retired, previously working as a clerk in the civil service. She currently lives together with her son after being widowed two years ago. She had never smoked or been exposed to cigarette smoke in the house. She achieved menopause more than 10 years ago and has never been on hormone replacement therapy.
Physical examination
Maimon was alert but looked pale and fatigued. Her nutritional status was good. There was pallor with no evidence of jaundice. Oral hygiene was good. No facial rash, petechiae or purpura was noted. There was no peripheral lymphadenopathy.
Her weight was 56kg with height of 165cm. Her vital signs were: PR: 80/min, BP: 130/70mmHg, RR: 18/min and temperature of 37oC.
Cardiovascular examination showed normal heart sounds with no murmurs. Lungs appeared clear. No palpable masses were detected on abdominal examination. Liver and spleen were not palpable.
There was diffuse bone tenderness especially along the spine with mild generalised muscle weakness. No focal neurological deficits were identified neither were there any joint deformities or swelling.
Tasks (Part I) – hypothesis generation
- List three possible diagnosis in order of likelihood (principal diagnosis and differential/other diagnosis).
- For each possible diagnosis listed, provide findings from the history and clinical examinations or patient risk factors that would support your diagnosis.
- For each possible diagnosis listed, provide findings opposing the hypothesis, or findings that were expected but not present or elicited during the clinical examination.
- Based on your reasoning above, decide on the first-line laboratory and imaging tests that you would want to perform in the patient. For each test, state how the results may help you to affirm or disprove your hypothesis.
Investigations (first-line)
Haematology & Clinical Chemistry
| Reference range | Units | ||
| Full blood count | |||
| WBC | 8.2 | 4.0 – 11.0 | 109/L |
| RBC | 2.8 | 3.8 – 4.8 | 1012/L |
| Hb | 75 | 120 – 160 | g/L |
| Hct | 0.27 | 0.37 – 0.47 | |
| MCV | 96 | 77 – 97 | fL |
| MCH | 27 | 27 – 32 | pg |
| MCHC | 355 | 315 – 345 | g/L |
| RDW | 14.9 | 11.5 – 15.0 | % |
| Platelet | 164 | 150 – 400 | 109/L |
| Total white differential counts | |||
| Neutrophils | 2.4 | 2.0 – 7.5 | 109/L |
| Lymphocytes | 3.6 | 1.5 – 4.0 | 109/L |
| Monocytes | 1.8 | 0.7 – 1.5 | 109/L |
| Eosinophils | 0.4 | 0.3 – 0.8 | 109/L |
| Basophils | 0.02 | 0.02 – 0.1 | 109/L |
| Serum electrolytes | |||
| Sodium | 134 | 135 – 148 | mmol/L |
| Potassium | 4.7 | 3.5 – 5.5 | mmol/L |
| Chloride | 96 | 95 – 105 | mmol/L |
| Calcium | 3.1 | 2.1 – 2.7 | mmol/L |
| Magnesium | 1.0 | 0.7 – 1.0 | mmol/L |
| Urea | 7.4 | 2.5 – 6.5 | mmol/L |
| Creatinine | 186 | 45 – 120 | mmol/L |
| Serum proteins | |||
| Total protein | 95 | 64 – 83 | g/L |
| Albumin | 30 | 35 – 50 | g/L |
Peripheral Blood Film
Red cells are reduced in numbers and appear normochromic normocytic. No significant anisopoikilocytosis or polychromasia is noted. Red cell showing rouleauxing is however noted with rare NRBCs. Platelets and white cells are seen in adequate numbers and do not show left shifted maturation or significant morphological abnormalities.
Impression: Normochromic normocytic anaemia with possible underlying gammopathy.
Imaging

Lumbar spine – anterior-posterior view
Osteolytic lesion with cortical breakthrough and collapse of L3 vertebrae. Adjacent soft tissue mass is present.
Tasks (Part II) – information integration and interpretation
- Refine your diagnosis based on the results of the investigation and reprioritise if necessary
- Formulate the next steps in investigation for confirmation of diagnosis, patient assessment prior to treatment initiation and prognostication
Investigations (additional)
Serum and urinary immunoglobulins
| Reference range | Units | ||
| Serum immunoglobulins | |||
| IgG | 5.0 | 6.0 – 16.0 | g/L |
| IgA | 45.0 | 0.8 – 4.0 | g/L |
| IgM | 0.4 | 0.5 – 2.0 | g/L |
| IgE | 0.02 | < 0.1 | g/L |
| IgD | 0.1 | < 0.1 | g/L |
| Free light chains (lambda) | 120.0 | 5.7 – 26.3 | g/L |
| Free light chains (kappa) | 15.0 | 3.3 – 19.4 | g/L |
| Urine for Bence Jones | |||
| Bence-Jones protein | Positive | ||
Serum protein electrophoresis

Haematology – bone marrow examination

Tasks (Part III) – mechanistic diagram and management
- Develop a mechanistic diagram outlining the scientific mechanisms behind the major signs, symptoms and laboratory results seen in the patient
- Develop a basic care plan for the patient which should address the physical, mental, and social wellbeing needs of the patient